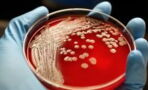
Forscher finden heraus: Dieses Bakterium hat es auf menschliches Blut abgesehen

Seit Jahrhunderten versuchen Alchemisten dem Geheimnis auf die Spur zu kommen, wertlose Metalle in einen wertvollen Stoff zu verwandeln: Gold! Doch bis heute hat es kein Mensch geschafft, das Wunder zu vollbringen. Ein Alchemist der außergewöhnlichen Art scheint nun in der Lage zu sein, das Undenkbare zu verwirklichen und den Schlüssel zur Transformation von Metallen zu kennen. Sein Name: Cupriavidus metallidurans. Hinter dem Namen verbirgt sich kein Genie und auch kein orientalischer Magier. Nein, bei Cupriavidus metallidurans handelt es sich um ein schlichtes Bakterium.
Der Mikroorganismus, der kleine Goldnuggets produzieren kann, hat schon im Jahr 2009 von sich reden gemacht, als Wissenschaftler seine unglaubliche Fähigkeit entdeckten. Doch damals konnten sie nicht herausfinden, mit welcher Methode Cupriavidus metallidurans das Wunder vollbringt. Für sie blieb es ein Geheimnis, wie es das Bakterium anstellt, ohne sich zu vergiften.
So kann es höchst giftige Verbindungen aus dem Boden aufnehmen, die durch Gold und seine Ionen entstehen, und diese in das wertvolle Metall verwandeln. „Die Ergebnisse der Studie zeigen sein Vorgehen bei der Entgiftung von Goldkomplexen und die daraus resultierende Entstehung von Gold," erklärte 2009 der Mikrobiologe Frank Reith von der Adelaide University in Australien.
Der Vorgang bei der Umwandlung ist endlich bekannt
In dem Magazin Metallomics, das von der Royal Society of Chemistry herausgegeben wird, geben der Wissenschaftler und sein Team nun bekannt, dass das Geheimnis um den Prozess nun gelüftet ist. Der Mechanismus, der das Bakterium vor Vergiftung schützt, betrifft nicht nur Gold, sondern auch Kupfer.
Um sich vor den giftigen Schwermetallen zu schützen, greift das Bakterium auf zwei Enzyme zurück. Das erste von ihnen heißt CupA. Das Enzym hilft dem Bakterium, sich von dem schädlichen Kupfer zu befreien. Das einzige Problem: In Verbindung mit Gold, kann das Enzym nichts gegen den giftigen Effekt ausrichten.
„Wenn ebenfalls Goldverbindungen vorhanden sind, ist das Enzym blockiert und die giftigen Gold- und Kupferverbindungen gelangen in das Innere der Zelle,“ schreibt der Mitverantwortliche der Studie, Dietrich H. Nies, von der Martin Luther Universität in Halle-Wittenberg in einer Mitteilung.
Ein weiteres Enzym schaltet sich ein
Zur Unterstützung von CupA, schaltet sich das Enzym CopA ein. Dieses ist in der Lage, sowohl Kupfer als auch Gold in schwer aufzunehmende Stoffe umzuwandeln. Auf diese Weise hilft es Cupriavidus metallidurans, die Stoffe loszuwerden. „Dadurch gelangen die Kupfer- und Goldverbindungen nicht in das Innere der Zelle. Dies schützt das Bakterium vor Vergiftung und sorgt dafür, dass nicht zu viel Kupfer in seine Zellen eindringt,“ erklärt Dietrich H. Nies.
Nach dieser ersten Phase der Entgiftung, erfolgt die Umformung der Goldverbindungen in schwer aufnehmbare feste Bestandteile, die sich dann an der Zellwand ablagern. Dabei haben diese Goldpartikel nur einen Durchmesser von einigen Nanometern, die zusammen einen Teppich von winzigen Goldnuggets ergeben. Das reicht noch nicht, um Schmuck daraus zu machen. Doch wer weiß, vielleicht kann man die Bakterien schon bald zur Gewinnung von Gold nutzen.
Dank der Arbeit der Forscher ist man dem Geheimnis nun ein Stück näher, wie Gold entsteht, transportiert wird und sich in tieferen Erdschichten ansammelt: Der geochemische Kreislauf von Gold. Ein weiterer Schritt hin zum Verständnis, wie man aus dem Bakterium nicht nur geringste Mengen an Gold schöpfen kann. Vielleicht birgt Cupriavidus metallidurans ja das große Geheimnis der Alchemie.